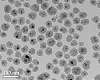

|

|
Space Tourism and Business Looking Up Washington DC (VOA) Mar 09, 2017 It was a surprising announcement: SpaceX, a private company, said it will fly two people to the moon next year. This has not been attempted since NASA's Apollo moon landings about 45 years ago. The news came from SpaceX founder and chief executive officer, Elon Musk. He is a billionaire who made his money from technology. In a news conference, he said two people have already paid SpaceX a "significant" amount of money to send them on a weeklong flight just beyond the moon and back. No one has been ... read more |
 Silent Sentry: Defending the final frontier
Silent Sentry: Defending the final frontierAl Udeid Air Base, Qatar (AFNS) Mar 07, 2017 Air, space and cyberspace - these are the three domains that the United States Air Force strives to defend. Of these domains, space has become one of the most crowded and competitive. At any given t ... more  Taking earth's inner temperature
Taking earth's inner temperatureCape Cod MA (SPX) Mar 03, 2017 The temperature of Earth's interior affects everything from the movement of tectonic plates to the formation of the planet. A new study led by Woods Hole Oceanographic Institution (WHOI) suggests th ... more  Warped Meteor Showers Hit Earth at All Angles
Warped Meteor Showers Hit Earth at All AnglesMountain View CA (SPX) Mar 09, 2017 Some meteor showers persist for weeks and months, even though Earth sweeps a big arc around the Sun during that time. The meteors arrive from a slightly different direction each day, which is a clue ... more  New Plant Habitat Will Increase Harvest on International Space Station
New Plant Habitat Will Increase Harvest on International Space StationKennedy Space Center FL (SPX) Mar 07, 2017 A new, nearly self-sufficient plant growth system by NASA is headed to the International Space Station soon and will help researchers better understand how plants grow in space. The Advanced Plant H ... more |
| Previous Issues | Mar 08 | Mar 07 | Mar 06 | Mar 05 | Mar 04 |
|
|
 Long-Lasting Cryovolcanism on Dwarf Planet Ceres
Long-Lasting Cryovolcanism on Dwarf Planet CeresGottingen, Germany (SPX) Mar 07, 2017 Among the most striking features on the surface of Ceres are the bright spots in the center of Occator crater, which stood out already as NASA's space probe Dawn approached the dwarf planet. Scienti ... more  China Plans to Launch 1st Probe to Mars in Summer 2020
China Plans to Launch 1st Probe to Mars in Summer 2020Beijing (Sputnik) Mar 09, 2017 China is expected to launch its first probe satellite to Mars in July or in August 2020, local media reported Tuesday. The People's Daily newspaper reported citing Wan Weixing, an academician ... more  Dawn Identifies Age of Ceres' Brightest Area
Dawn Identifies Age of Ceres' Brightest AreaPasadena CA (JPL) Mar 09, 2017 The bright central area of Ceres' Occator Crater, known as Cerealia Facula, is approximately 30 million years younger than the crater in which it lies, according to a new study in the Astronomical J ... more  Earth is bombarded at random
Earth is bombarded at randomZurich, Switzerland (SPX) Mar 09, 2017 Do mass extinctions, like the fall of the dinosaurs, and the formation of large impact craters on Earth occur together at regular intervals? "This question has been under discussion for more than th ... more  Ancient Stardust Sheds Light on the First Stars
Ancient Stardust Sheds Light on the First StarsMunich, Germany (SPX) Mar 09, 2017 Astronomers have used ALMA to detect a huge mass of glowing stardust in a galaxy seen when the universe was only four percent of its present age. This galaxy was observed shortly after its formation ... more  Kymeta and Intelsat announce new service to revolutionize how satellite services are purchased
Kymeta and Intelsat announce new service to revolutionize how satellite services are purchasedWashington DC (SPX) Mar 09, 2017 Kymeta and Intelsat have joined forces to offer a new, groundbreaking, satellite service offering that is easy to buy and use. The new KALO service, which will become available in Q3 2017, will intr ... more |
 Kepler Provides Another Peek at Ultra-cool Neighbor  Russia to arm Antey nuclear subs with Kalibr missiles
Russia to arm Antey nuclear subs with Kalibr missilesMoscow (UPI) Mar 07, 2017 Russian Project 949A Antey submarines will be armed with Kalibr missile systems following an upgrade project, according to state media reports. ... more  U.S. Naval Research Lab develops light, transparent armor
U.S. Naval Research Lab develops light, transparent armorWashington (UPI) Mar 8, 2017 U.S. Naval Research Laboratory scientists have developed and patented a transparent armor they say reduces weight while maintaining strong defensive properties. ... more  Underwater mountains help ocean water rise from abyss
Underwater mountains help ocean water rise from abyssBoston MA (SPX) Mar 07, 2017 At high latitudes, such as near Antarctica and the Arctic Circle, the ocean's surface waters are cooled by frigid temperatures and become so dense that they sink a few thousand meters into the ocean ... more Groundbreaking technology rewarms large-scale tissues preserved at low temperatures
Groundbreaking technology rewarms large-scale tissues preserved at low temperaturesMinneapolis MN (SPX) Mar 03, 2017 A research team, led by the University of Minnesota, has discovered a groundbreaking process to successfully rewarm large-scale animal heart valves and blood vessels preserved at very low temperatur ... more |

|
Kennedy Space Center FL (SPX) Mar 07, 2017  A new, nearly self-sufficient plant growth system by NASA is headed to the International Space Station soon and will help researchers better understand how plants grow in space. The Advanced Plant Habitat will be used to conduct plant bioscience research on the space station, and help NASA prepare crew to grow their own food in space during deep-space exploration missions.
Some of the comp ... more
A new, nearly self-sufficient plant growth system by NASA is headed to the International Space Station soon and will help researchers better understand how plants grow in space. The Advanced Plant Habitat will be used to conduct plant bioscience research on the space station, and help NASA prepare crew to grow their own food in space during deep-space exploration missions.
Some of the comp ... more Washington DC (VOA) Mar 09, 2017 Washington DC (VOA) Mar 09, 2017Space Tourism and Business Looking Up  New Delhi (XNA) Mar 03, 2017 New Delhi (XNA) Mar 03, 2017India has capability to develop space station, says top official  Washington DC (SPX) Mar 07, 2017 Washington DC (SPX) Mar 07, 2017NASA Releases Free Software Catalog |
Seattle WA (UPI) Mar 07, 2017  Jeff Bezos introduced the latest concept from his company Blue Origin at the Satellite 2017 conference, the New Glenn rocket, which features a reusable first stage. Blue Origin released a video detailing the rocket's specs.
The rocket doesn't exist yet, but it already has a customer. Satellite provider Eutelsat will be the rocket's first client.
"We couldn't hope for a better fir ... more
Jeff Bezos introduced the latest concept from his company Blue Origin at the Satellite 2017 conference, the New Glenn rocket, which features a reusable first stage. Blue Origin released a video detailing the rocket's specs.
The rocket doesn't exist yet, but it already has a customer. Satellite provider Eutelsat will be the rocket's first client.
"We couldn't hope for a better fir ... more Cayenne (AFP) March 7, 2017 Cayenne (AFP) March 7, 2017Europe launches fourth Earth monitoring satellite  San Francisco (AFP) March 5, 2017 San Francisco (AFP) March 5, 2017Elon Musk: tech dreamer reaching for sun, moon and stars  Eglin AFB FL (SPX) Mar 07, 2017 Eglin AFB FL (SPX) Mar 07, 2017Space squadron supports record-breaking satellites launch |
|
|
Berkeley CA (SPX) Mar 07, 2017  Mars may have been a wetter place than previously thought, according to research on simulated Martian meteorites conducted, in part, at the Department of Energy's Lawrence Berkeley National Laboratory (Berkeley Lab).
In a study published in the journal Nature Communications, researchers found evidence that a mineral found in Martian meteorites - which had been considered as proof of an anc ... more
Mars may have been a wetter place than previously thought, according to research on simulated Martian meteorites conducted, in part, at the Department of Energy's Lawrence Berkeley National Laboratory (Berkeley Lab).
In a study published in the journal Nature Communications, researchers found evidence that a mineral found in Martian meteorites - which had been considered as proof of an anc ... more Houston (Sputnik) Mar 03, 2017 Houston (Sputnik) Mar 03, 2017Humans May Quickly Evolve on Mars, Biologist Claims  Pasadena CA (JPL) Mar 03, 2017 Pasadena CA (JPL) Mar 03, 2017NASA Orbiter Steers Clear of Mars Moon Phobos  Paris (ESA) Mar 03, 2017 Paris (ESA) Mar 03, 2017Remnants of a mega-flood on Mars |
Beijing (XNA) Mar 07, 2017  After sending a probe to Mars in 2020, China plans to explore three asteroids and land on one of them to conduct scientific research, according to a Chinese asteroid research expert.
The "China's Space Activities in 2016" white paper, issued by the Information Office of the State Council recently, also mentioned asteroid exploration in outlining the major tasks of the country's space indus ... more
After sending a probe to Mars in 2020, China plans to explore three asteroids and land on one of them to conduct scientific research, according to a Chinese asteroid research expert.
The "China's Space Activities in 2016" white paper, issued by the Information Office of the State Council recently, also mentioned asteroid exploration in outlining the major tasks of the country's space indus ... more Beijing (XNA) Mar 07, 2017 Beijing (XNA) Mar 07, 2017China's 1st cargo spacecraft to make three rendezvous with Tiangong-2  Beijing (Sputnik) Mar 09, 2017 Beijing (Sputnik) Mar 09, 2017China Plans to Launch 1st Probe to Mars in Summer 2020  Jiuquan (XNA) Mar 07, 2017 Jiuquan (XNA) Mar 07, 2017China launches experiment satellite "TK-1" |
|
|
Washington DC (SPX) Mar 09, 2017  Kymeta and Intelsat have joined forces to offer a new, groundbreaking, satellite service offering that is easy to buy and use. The new KALO service, which will become available in Q3 2017, will introduce a simplified way to buy and sell connectivity to customers and sectors that are currently unreached or underserved by terrestrial networks. KALO will change the way satellite services are purcha ... more
Kymeta and Intelsat have joined forces to offer a new, groundbreaking, satellite service offering that is easy to buy and use. The new KALO service, which will become available in Q3 2017, will introduce a simplified way to buy and sell connectivity to customers and sectors that are currently unreached or underserved by terrestrial networks. KALO will change the way satellite services are purcha ... more McLean, VA (SPX) Mar 07, 2017 McLean, VA (SPX) Mar 07, 2017Iridium Safety Voice Communications Installs Surge Past 500 Aircraft  Washington DC (SPX) Mar 08, 2017 Washington DC (SPX) Mar 08, 2017Eutelsat Signs up for Blue Origin's New Glenn Launcher  Moscow (Sputnik) Mar 03, 2017 Moscow (Sputnik) Mar 03, 2017Turkey Moves Closer to Launching Own Space Agency |
Madrid, Spain (SPX) Mar 07, 2017  Aireon has announced that Thales has officially begun the testing and validation of the Aireon space-based Automatic Dependent Surveillance - Broadcast (ADS-B) data. Initially signing a Memorandum of Understanding (MOU) in June of 2015, the start of data validation marks a major milestone for Aireon and Thales' efforts to ensure the successful integration of space-based ADS-B into the TopSky-ATC ... more
Aireon has announced that Thales has officially begun the testing and validation of the Aireon space-based Automatic Dependent Surveillance - Broadcast (ADS-B) data. Initially signing a Memorandum of Understanding (MOU) in June of 2015, the start of data validation marks a major milestone for Aireon and Thales' efforts to ensure the successful integration of space-based ADS-B into the TopSky-ATC ... more Washington (UPI) Mar 8, 2017 Washington (UPI) Mar 8, 2017U.S. Naval Research Lab develops light, transparent armor  Canberra (UPI) Mar 07, 2017 Canberra (UPI) Mar 07, 2017Space surveillance radar system fully operational  Chicago IL (SPX) Mar 07, 2017 Chicago IL (SPX) Mar 07, 2017Bubble-recoil could be used to cool microchips, even in space |
|
|
Pasadena CA (JPL) Mar 09, 2017  On Feb. 22, astronomers announced that the ultra-cool dwarf star, TRAPPIST-1, hosts a total of seven Earth-size planets that are likely rocky, a discovery made by NASA's Spitzer Space Telescope in combination with ground-based telescopes. NASA's planet-hunting Kepler space telescope also has been observing this star since December 2016. Today these additional data about TRAPPIST-1 from Kepler ar ... more
On Feb. 22, astronomers announced that the ultra-cool dwarf star, TRAPPIST-1, hosts a total of seven Earth-size planets that are likely rocky, a discovery made by NASA's Spitzer Space Telescope in combination with ground-based telescopes. NASA's planet-hunting Kepler space telescope also has been observing this star since December 2016. Today these additional data about TRAPPIST-1 from Kepler ar ... more Washington DC (SPX) Mar 03, 2017 Washington DC (SPX) Mar 03, 2017Hunting for giant planet analogs in our own backyard  Canberra, Australia (SPX) Mar 03, 2017 Canberra, Australia (SPX) Mar 03, 2017Faraway Planet Systems Are Shaped Like the Solar System  Washington DC (SPX) Mar 03, 2017 Washington DC (SPX) Mar 03, 2017Biochemical 'fossil' shows how life may have emerged without phosphate |
Pasadena CA (JPL) Feb 21, 2017  NASA's Juno mission to Jupiter, which has been in orbit around the gas giant since July 4, 2016, will remain in its current 53-day orbit for the remainder of the mission. This will allow Juno to accomplish its science goals, while avoiding the risk of a previously-planned engine firing that would have reduced the spacecraft's orbital period to 14 days.
"Juno is healthy, its science instrum ... more
NASA's Juno mission to Jupiter, which has been in orbit around the gas giant since July 4, 2016, will remain in its current 53-day orbit for the remainder of the mission. This will allow Juno to accomplish its science goals, while avoiding the risk of a previously-planned engine firing that would have reduced the spacecraft's orbital period to 14 days.
"Juno is healthy, its science instrum ... more Pasadena CA (JPL) Feb 22, 2017 Pasadena CA (JPL) Feb 22, 2017Europa Flyby Mission Moves into Design Phase  Pasadena CA (JPL) Feb 10, 2017 Pasadena CA (JPL) Feb 10, 2017NASA receives science report on Europa lander concept  Laurel MD (SPX) Feb 03, 2017 Laurel MD (SPX) Feb 03, 2017New Horizons Refines Course for Next Flyby |
|
|
Boston MA (SPX) Mar 07, 2017  At high latitudes, such as near Antarctica and the Arctic Circle, the ocean's surface waters are cooled by frigid temperatures and become so dense that they sink a few thousand meters into the ocean's abyss.
Ocean waters are thought to flow along a sort of conveyor belt that transports them between the surface and the deep in a never-ending loop. However, it remains unclear where the deep ... more
At high latitudes, such as near Antarctica and the Arctic Circle, the ocean's surface waters are cooled by frigid temperatures and become so dense that they sink a few thousand meters into the ocean's abyss.
Ocean waters are thought to flow along a sort of conveyor belt that transports them between the surface and the deep in a never-ending loop. However, it remains unclear where the deep ... more Stanford CA (SPX) Mar 09, 2017 Stanford CA (SPX) Mar 09, 2017Stanford biologists identify ancient stress response in corals  Urbana IL (SPX) Mar 09, 2017 Urbana IL (SPX) Mar 09, 2017Chicago waterways still flowing after over 100 years  Jerusalem (AFP) March 7, 2017 Jerusalem (AFP) March 7, 2017Sea of Galilee water level lowest in century: official |
Los Angeles CA (UPI) Mar 07, 2017  Raytheon is closer to delivering next-generation capabilities for the U.S. Air Force-led Global Positioning System Operational Control System project.
The company recently announced the completion of a major engineering milestone for the project, also referred to as GPS OCX. The work was conducted over a two-year period, and consisted of software development with a focus on cybersecurit ... more
Raytheon is closer to delivering next-generation capabilities for the U.S. Air Force-led Global Positioning System Operational Control System project.
The company recently announced the completion of a major engineering milestone for the project, also referred to as GPS OCX. The work was conducted over a two-year period, and consisted of software development with a focus on cybersecurit ... more Beijing (AFP) Feb 21, 2017 Beijing (AFP) Feb 21, 2017Police in China's restive Xinjiang to track cars by GPS  New Delhi (Sputnik) Feb 15, 2017 New Delhi (Sputnik) Feb 15, 2017GLONASS station in India to expedite 'space centric' warfare command  Canberra, Australia (SPX) Feb 14, 2017 Canberra, Australia (SPX) Feb 14, 2017Australia and Lockheed field 2nd-Gen sat-based augmentation system |
|
|
Moscow (Sputnik) Mar 03, 2017  ISRO boss AS Kiran Kumar says the second lunar mission Chandrayaan 2 is making good progress; it is scheduled for launch next year. But critics question why should India get into the manned spaceflight race when the US and Russia have scaled back.
The Indian Space Research Organization (ISRO) is on course to develop an engine for the moon mission Chandrayaan-2, said ISRO chairman AS Kiran ... more
ISRO boss AS Kiran Kumar says the second lunar mission Chandrayaan 2 is making good progress; it is scheduled for launch next year. But critics question why should India get into the manned spaceflight race when the US and Russia have scaled back.
The Indian Space Research Organization (ISRO) is on course to develop an engine for the moon mission Chandrayaan-2, said ISRO chairman AS Kiran ... more Houston TX (SPX) Feb 28, 2017 Houston TX (SPX) Feb 28, 2017An Epic Lunar Experience Lands at Space Center Houston  New Delhi (Sputnik) Feb 17, 2017 New Delhi (Sputnik) Feb 17, 2017India Takes Russian Help to Analyze Chemical Composition of Lunar Surface  Moscow (Sputnik) Feb 01, 2017 Moscow (Sputnik) Feb 01, 2017Complete Lunar-cy: The Earth Has Sprayed the Moon With Oxygen for Billennia |
Zurich (UPI) Mar 7, 2017  New analysis of Earth's myriad craters turned up no evidence of an impact pattern. Earth is bombarded at random, the research shows.
Some astronomers suggest the sun possesses a companion star, which makes its closest approach to the solar system every 26 million years, triggering a barrage of asteroids. But the sibling star, named Nemesis, has never been found, and the latest analysis ... more
New analysis of Earth's myriad craters turned up no evidence of an impact pattern. Earth is bombarded at random, the research shows.
Some astronomers suggest the sun possesses a companion star, which makes its closest approach to the solar system every 26 million years, triggering a barrage of asteroids. But the sibling star, named Nemesis, has never been found, and the latest analysis ... more Gottingen, Germany (SPX) Mar 07, 2017 Gottingen, Germany (SPX) Mar 07, 2017Long-Lasting Cryovolcanism on Dwarf Planet Ceres  Mountain View CA (SPX) Mar 09, 2017 Mountain View CA (SPX) Mar 09, 2017Warped Meteor Showers Hit Earth at All Angles  Zurich, Switzerland (SPX) Mar 09, 2017 Zurich, Switzerland (SPX) Mar 09, 2017Earth is bombarded at random |
|
|
Cape Cod MA (SPX) Mar 03, 2017  The temperature of Earth's interior affects everything from the movement of tectonic plates to the formation of the planet. A new study led by Woods Hole Oceanographic Institution (WHOI) suggests the mantle - the mostly solid, rocky part of Earth's interior that lies between its super-heated core and its outer crustal layer - may be hotter than previously believed. The new finding, published Mar ... more
The temperature of Earth's interior affects everything from the movement of tectonic plates to the formation of the planet. A new study led by Woods Hole Oceanographic Institution (WHOI) suggests the mantle - the mostly solid, rocky part of Earth's interior that lies between its super-heated core and its outer crustal layer - may be hotter than previously believed. The new finding, published Mar ... more Greenbelt MD (SPX) Mar 03, 2017 Greenbelt MD (SPX) Mar 03, 2017TRIPLESAT Constellation Tasking with SpyMeSat Mobile App  Sydney (AFP) March 8, 2017 Sydney (AFP) March 8, 2017'Angry' Australian summer weather smashes records  Greenbelt MD (SPX) Mar 07, 2017 Greenbelt MD (SPX) Mar 07, 2017NASA examines deadly spring-like weather with GPM satellite |
Copenhagen, Denmark (UPI) Mar 3, 2017  New research shows solar storms leave large portions of Earth's atmosphere without electrons.
Typically, when a solar storm reaches Earth, the collision with the planet's magnetosphere creates space through which a barrage of charged particles and electrons flood the ionosphere, an outer layer of Earth's atmosphere.
In other words, solar storms are most often associated with an e ... more New research shows solar storms leave large portions of Earth's atmosphere without electrons.
Typically, when a solar storm reaches Earth, the collision with the planet's magnetosphere creates space through which a barrage of charged particles and electrons flood the ionosphere, an outer layer of Earth's atmosphere.
In other words, solar storms are most often associated with an e ... more Washington DC (SPX) Mar 01, 2017 Washington DC (SPX) Mar 01, 2017First Solar Images from NOAA's GOES-16 Satellite  Washington (UPI) Feb 25, 2017 Washington (UPI) Feb 25, 2017Rare 'Ring of Fire' eclipse to cross Southern Hemisphere  Tucson AZ (SPX) Feb 24, 2017 Tucson AZ (SPX) Feb 24, 2017NSF to Fund a Nationwide Effort to Capture the Eclipse |
|
|
Munich, Germany (SPX) Mar 09, 2017  Astronomers have used ALMA to detect a huge mass of glowing stardust in a galaxy seen when the universe was only four percent of its present age. This galaxy was observed shortly after its formation and is the most distant galaxy in which dust has been detected. This observation is also the most distant detection of oxygen in the universe. These new results provide brand-new insights into the bi ... more
Astronomers have used ALMA to detect a huge mass of glowing stardust in a galaxy seen when the universe was only four percent of its present age. This galaxy was observed shortly after its formation and is the most distant galaxy in which dust has been detected. This observation is also the most distant detection of oxygen in the universe. These new results provide brand-new insights into the bi ... more Johannesburg, South Africa (SPX) Mar 07, 2017 Johannesburg, South Africa (SPX) Mar 07, 2017HERA Radio Telescope Attracts Even More International Funding  Santa Cruz de Tenerife, Spain (SPX) Mar 07, 2017 Santa Cruz de Tenerife, Spain (SPX) Mar 07, 2017Revealing the origin and nature of the outskirts of stellar megalopolises  Santa Cruz de Tenerife, Spain (SPX) Mar 07, 2017 Santa Cruz de Tenerife, Spain (SPX) Mar 07, 2017A new look at the nature of dark matter |
Pasadena CA (JPL) Mar 07, 2017  This summer, an ice chest-sized box will fly to the International Space Station, where it will create the coolest spot in the universe. Inside that box, lasers, a vacuum chamber and an electromagnetic "knife" will be used to cancel out the energy of gas particles, slowing them until they're almost motionless. This suite of instruments is called the Cold Atom Laboratory (CAL), and was developed b ... more
This summer, an ice chest-sized box will fly to the International Space Station, where it will create the coolest spot in the universe. Inside that box, lasers, a vacuum chamber and an electromagnetic "knife" will be used to cancel out the energy of gas particles, slowing them until they're almost motionless. This suite of instruments is called the Cold Atom Laboratory (CAL), and was developed b ... more Boston MA (SPX) Mar 07, 2017 Boston MA (SPX) Mar 07, 2017OLYMPUS experiment sheds light on structure of protons  College Park MD (SPX) Mar 03, 2017 College Park MD (SPX) Mar 03, 2017Rapid changes point to origin of ultra-fast black hole 'burps'  Washington DC (SPX) Mar 09, 2017 Washington DC (SPX) Mar 09, 2017Synchrotron sheds light on carbon chemistry at ocean surfaces |

|
| Buy Advertising | Media Advertising Kit | Editorial & Other Enquiries | Privacy statement |
| The content herein, unless otherwise known to be public domain, are Copyright 1995-2016 - Space Media Network. All websites are published in Australia and are solely subject to Australian law and governed by Fair Use principals for news reporting and research purposes. AFP, UPI and IANS news wire stories are copyright Agence France-Presse, United Press International and Indo-Asia News Service. ESA news reports are copyright European Space Agency. All NASA sourced material is public domain. Additional copyrights may apply in whole or part to other bona fide parties. Advertising does not imply endorsement, agreement or approval of any opinions, statements or information provided by Space Media Network on any Web page published or hosted by Space Media Network. Privacy Statement |